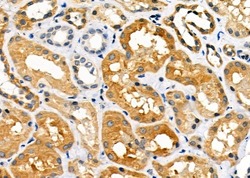

Antibody data
- Antibody Data
- Antigen structure
- References [0]
- Comments [0]
- Validations
- Western blot [1]
- Immunocytochemistry [2]
- Immunohistochemistry [5]
Submit
Validation data
Reference
Comment
Report error
- Product number
- PA5-99611 - Provider product page

- Provider
- Invitrogen Antibodies
- Product name
- COX7A2/COX7A3 Polyclonal Antibody
- Antibody type
- Polyclonal
- Antigen
- Synthetic peptide
- Description
- Antibody detects endogenous levels of total COX7a2/3.
- Reactivity
- Human, Mouse, Rat
- Host
- Rabbit
- Isotype
- IgG
- Vial size
- 100 μL
- Concentration
- 1 mg/mL
- Storage
- -20°C
No comments: Submit comment
Supportive validation
- Submitted by
- Invitrogen Antibodies (provider)
- Main image

- Experimental details
- Western blot analysis of COX7A2/COX7A3 in mouse muscle. Samples were incubated with COX7A2/COX7A3 polyclonal antibody (Product # PA5-99611).
Supportive validation
- Submitted by
- Invitrogen Antibodies (provider)
- Main image

- Experimental details
- Immunofluorescent analysis of COX7A2/COX7A3 in HeLa cells. Samples were fixed with paraformaldehyde, permeabilized with 0.1% Triton X-100, blocked with 10% serum (45 min at 25°C), incubated with mouse anti-beta tubulin and COX7A2/COX7A3 polyclonal antibody (Product # PA5-99611) using a dilution of 1:200 (1 hr, 37°C), and followed by goat anti-rabbit IgG Alexa Fluor 594 (red) and goat anti-mouse IgG Alexa Fluor 488 (green).
- Submitted by
- Invitrogen Antibodies (provider)
- Main image

- Experimental details
- Immunofluorescent analysis of COX7A2/COX7A3 in HeLa cells. Samples were fixed with paraformaldehyde, permeabilized with 0.1% Triton X-100, blocked with 10% serum (45 min at 25°C), incubated with mouse anti-beta tubulin and COX7A2/COX7A3 polyclonal antibody (Product # PA5-99611) using a dilution of 1:200 (1 hr, 37°C), and followed by goat anti-rabbit IgG Alexa Fluor 594 (red) and goat anti-mouse IgG Alexa Fluor 488 (green).
Supportive validation
- Submitted by
- Invitrogen Antibodies (provider)
- Main image

- Experimental details
- Immunohistochemistry analysis of COX7A2/COX7A3 in mouse kidney tissue. The sample was formaldehyde fixed and a heat mediated antigen retrieval step in citrate buffer was performed. Samples were incubated with COX7A2/COX7A3 polyclonal antibody (Product # PA5-99611) using a dilution of 1:100 (4°C overnight) followed by HRP conjugated anti-Rabbit secondary antibody.
- Submitted by
- Invitrogen Antibodies (provider)
- Main image

- Experimental details
- Immunohistochemistry analysis of COX7A2/COX7A3 in human kidney cancer and adjacent normal tissues. The sample was formaldehyde fixed and a heat mediated antigen retrieval step in citrate buffer was performed. Samples were incubated with COX7A2/COX7A3 polyclonal antibody (Product # PA5-99611) using a dilution of 1:100 (4°C overnight) followed by HRP conjugated anti-Rabbit secondary antibody.
- Submitted by
- Invitrogen Antibodies (provider)
- Main image

- Experimental details
- Immunohistochemistry analysis of COX7A2/COX7A3 in rat heart tissue. The sample was formaldehyde fixed and a heat mediated antigen retrieval step in citrate buffer was performed. Samples were incubated with COX7A2/COX7A3 polyclonal antibody (Product # PA5-99611) using a dilution of 1:100 (4°C overnight) followed by HRP conjugated anti-Rabbit secondary antibody.
- Submitted by
- Invitrogen Antibodies (provider)
- Main image
- Experimental details
- Immunohistochemistry analysis of COX7A2/COX7A3 in human kidney cancer and adjacent normal tissues. The sample was formaldehyde fixed and a heat mediated antigen retrieval step in citrate buffer was performed. Samples were incubated with COX7A2/COX7A3 polyclonal antibody (Product # PA5-99611) using a dilution of 1:100 (4°C overnight) followed by HRP conjugated anti-Rabbit secondary antibody.
- Submitted by
- Invitrogen Antibodies (provider)
- Main image

- Experimental details
- Immunohistochemistry analysis of COX7A2/COX7A3 in rat heart tissue. The sample was formaldehyde fixed and a heat mediated antigen retrieval step in citrate buffer was performed. Samples were incubated with COX7A2/COX7A3 polyclonal antibody (Product # PA5-99611) using a dilution of 1:100 (4°C overnight) followed by HRP conjugated anti-Rabbit secondary antibody.